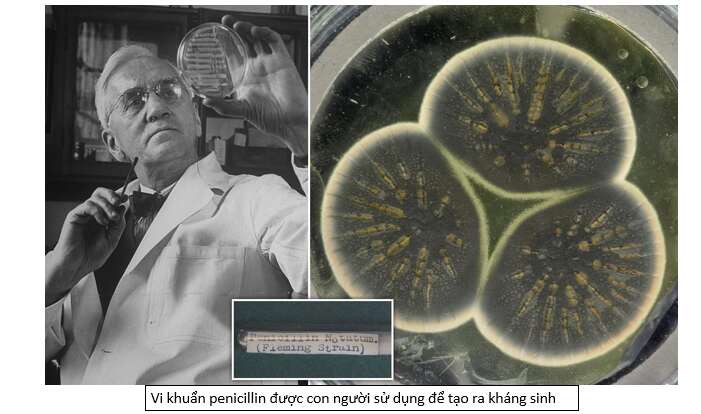
Lý thuyết Sinh học 10 Bài 21 (Kết nối tri thức): Trao đổi chất, sinh trưởng và sinh sản ở vi sinh vật (ảnh 14)

Giải bài tập Sinh học lớp 10 Bài 21: Trao đổi chất, sinh trưởng và sinh sản ở vi sinh vật
Mở đầu (trang 122)
Giải Sinh học 10 trang 122 Kết nối tri thức
Mở đầu trang 122 Sinh học 10: Escherricia coli là một loại vi khuẩn sống trong đường tiêu hóa của người và động vật. Chúng sinh sản bằng cách phân đôi. Hãy tưởng tượng các em đang nuôi vi khuẩn E.coli, cứ sau 20 phút, các em chụp ảnh qua kính hiển vi và đếm số lượng vi khuẩn tại thời điểm đó (hình dưới). Theo em, sẽ có bao nhiêu vi khuẩn E.coli trong bức ảnh tiếp theo? Em có nhận xét gì quá trình sinh sản của chúng?
Phương pháp giải:
– Vi sinh vật có cấu trúc đơn giản, chúng có các cơ chế thích nghi với môi trường nên quá trình sinh sản nhanh, có một số loại vi khuẩn chỉ mất khoảng 20 phút cho một thế hệ sinh sản.
Lời giải:
– Khi quan sát vi sinh vật ở bức ảnh thứ 6, số lượng vi khuẩn sẽ tăng lên gấp đôi so với bức ảnh số 5 và số vi khuẩn đếm được là 32 tế bào vi khuẩn.
– Quá trình sinh sản của vi khuẩn rất nhanh, chúng sinh sản theo hàm số mũ. Ở thế hệ ban đầu (bức ảnh số 1) chỉ có 1 tế bào vi khuẩn; thế hệ 1 (bức ảnh số 2) có 2 = 21 tế bào vi khuẩn; …;thế hệ thứ 4 (bức ảnh số 5) có 16 = 24 tế bào vi khuẩn. Cứ như vậy, ở thế hệ thứ n sẽ có 2n tế bào vi khuẩn được tạo ra.
Dừng lại và suy ngẫm (trang 124, 125, 128, 129)
Giải Sinh học 10 trang 124 Kết nối tri thức
Câu hỏi 1 trang 124 Sinh học 10: Nêu một số ví dụ về quá trình tổng hợp và phân giải các chất ở vi sinh vật.
Phương pháp giải:
– Quá trình tổng hợp các chất ở vi sinh vật còn gọi là quá trình đồng hóa, trong đó tế bào sử dụng năng lượng để liên kết các phân tử đơn giản thành các phân tử hữu cơ phức tạp cần thiết. Vi sinh vật có khả năng sinh tổng hợp tất cả các chất thiết yếu cho tế bào như cacbohydrate, protein, nucleic acid và lipid.
– Các vi sinh vật dị dưỡng phân giải các hợp chất hữu cơ do sinh vật khác cung cấp để lấy nguồn nguyên liệu cung cấp cho các hoạt động sống.
Lời giải:
– Ví dụ về quá trình tổng hợp và phân giải các chất ở vi sinh vật:
+ Quá trình tổng hợp ở vi sinh vật: tổng hợp protein từ các amino acid; tổng hợp lipid từ glycerol và acid béo,….
+ Quá trình phân giải ở vi sinh vật: phân giải đường đơn thành năng lượng qua hô hấp và lên men, phân giải protein thành các amino acid,…
Câu hỏi 2 trang 124 Sinh học 10: Quá trình tổng hợp và phân giải các chất ở vi sinh vật có gì giống và khác so với quá trình này ở động vật và thực vật?
Phương pháp giải:
– Quá trình tổng hợp các chất ở vi sinh vật còn gọi là quá trình đồng hóa, trong đó tế bào sử dụng năng lượng để liên kết các phân tử đơn giản thành các phân tử hữu cơ phức tạp cần thiết. Vi sinh vật có khả năng sinh tổng hợp tất cả các chất thiết yếu cho tế bào như cacbohydrate, protein, nucleic acid và lipid.
– Các vi sinh vật dị dưỡng phân giải các hợp chất hữu cơ do sinh vật khác cung cấp để lấy nguồn nguyên liệu cung cấp cho các hoạt động sống.
Lời giải:
So sánh quá trình tổng hợp và phân giải của vi sinh vật với động vật, thực vật
* Giống nhau:
– Sự tổng hợp các chất hay còn gọi là đồng hóa cả ở 3 đối tượng đều có bản chất là liên kết các phân tử đơn giản thành phân tử phức tạp hơn.
– Sự phân giải các chất hay còn gọi là dị hóa ở cả 3 đối tượng đều có bản chất là bẻ gãy các liên kết trong phân tử phức tạp thành phân tử đơn giản.
* Khác nhau:
– Do vi sinh vật có kích thước nhỏ, trong khi các chất cần phân giải lại có kích thước lớn nên chúng cần tiết enzyme ra bên ngoài tế bào để phân giải một phần sau đó mới hấp thụ vào trong để phân giải tiếp. Ở động vật, thực vật quá trình phân giải diễn ra bên trong tế bào, không có sự tiết enzyme ra bên ngoài tế bào.
Câu hỏi 3 trang 124 Sinh học 10: Theo em, người ta có thể ứng dụng quá trình phân giải đường đa và lipid ở vi sinh vật vào những lĩnh vực nào? Lấy ví dụ minh họa.
Phương pháp giải:
– Các vi sinh vật dị dưỡng phân giải các hợp chất hữu cơ do sinh vật khác cung cấp để lấy nguồn nguyên liệu cung cấp cho các hoạt động sống.
Lời giải:
– Người ta có thể ứng dụng quá trình phân giải đường đa ở vi sinh vật trong các lĩnh vực như:
+ Trong lĩnh vực môi trường: Sử dụng vi sinh vật phân giải chất mùn, chất xơ làm các loại phân bón vi sinh.
+ Trong lĩnh vực nông nghiệp: Sử dụng vi sinh vật phân giải xenlulozo tận dụng các bã thải thực vật (rơm, lõi bông, mía,…) để trồng nhiều loại nấm ăn.
+ Trong lĩnh vực thực phẩm: Sử dụng enzyme amilaza từ nấm mốc để thủy phân tinh bột trong sản xuất rượu.
– Người ta có thể ứng dụng quá trình phân giải lipid ở vi sinh vật trong các lĩnh vực như:
+ Trong lĩnh vực môi trường: Sử dụng vi sinh vật xử lý dầu loang trên mặt biển.
+ Trong lĩnh vực tiêu dùng: Sử dụng enzyme vi sinh vật lipaza để thêm vào bột giặt nhằm tẩy sạch các vết bẩn dầu mỡ gây nên.
Giải Sinh học 10 trang 125 Kết nối tri thức
Câu hỏi 1 trang 125 Sinh học 10: Khái niệm sinh trưởng ở vi sinh vật có gì khác so với sinh trưởng ở thực vật và động vật? Giải thích vì sao có sự khác nhau đó.
Phương pháp giải:
– Sự sinh trưởng của sinh vật bậc cao (động vật, thực vật) là sự gia tăng về khối lượng, kích thước của cơ thể từng cá thể.
– Sự sinh trưởng của quần thể vi sinh vật chỉ sự tăng lên về mặt số lượng tế bào trong quần thể.
Lời giải:
– Khái niệm sinh trưởng ở vi sinh vật: Sự sinh trưởng của quần thể vi sinh vật chỉ sự tăng lên về mặt số lượng tế bào trong quần thể.
– Khái niệm sinh trưởng ở vi sinh vật khác so với sinh trưởng ở động vật, thực vật ở chỗ:
+ Ở VSV: tăng lên về số lượng tế bào trong quần thể.
+ Ở động vật, thực vật tăng lên về khối lượng, kích thước của cơ thể của từng cá thể.
– Có sự khác biệt đó là do vi sinh vật chúng có kích thước rất nhỏ nên sự sinh trưởng về kích thước rất khó quan sát; vì vậy sự sinh trưởng sẽ được xét trên toàn bộ quần thể.
Câu hỏi 2 trang 125 Sinh học 10: Nêu điểm khác nhau giữa quá trình sinh trưởng của quần thể vi sinh vật trong môi trường nuôi cấy liên tục và môi trường nuôi cấy không liên tục. Tại sao lại có sự khác nhau đó?
Phương pháp giải:
– Nuôi cấy không liên tục: trong môi trường nuôi cấy không liên tục – môi trường không được bổ sung chất dinh dưỡng mới và không được lấy đi các sản phẩm trao đổi chất, sự sinh trưởng của vi khuẩn bao gồm 4 pha cơ bản: pha tiềm phát, pha lũy thừa, pha cân bằng và pha suy vong.
– Nuôi cấy liên tục: trong môi trường nuôi cấy liên tục thường xuyên được bổ sung chất dinh dưỡng và loại bỏ các sản phẩm trao đổi chất.
Lời giải:
– Sự khác nhau giữa nuôi cấy liên tục và nuôi cấy không liên tục

– Giải thích có sự khác biệt đó: do bản chất của 2 kiểu nuôi cấy
+ Nuôi cấy không liên tục – môi trường không được bổ sung chất dinh dưỡng mới và không được lấy đi các sản phẩm trao đổi chất, sự sinh trưởng của vi khuẩn bao gồm 4 pha cơ bản: pha tiềm phát, pha lũy thừa, pha cân bằng và pha suy vong.
+ Nuôi cấy liên tục: trong môi trường nuôi cấy liên tục thường xuyên được bổ sung chất dinh dưỡng và loại bỏ các sản phẩm trao đổi chất, vi sinh vật không cần pha tiềm phát do đã có sẵn enzyme để thích ứng với nguồn chất dinh dưỡng được bổ sung thêm, và không có sự suy vong.
Câu hỏi 3 trang 125 Sinh học 10: Trong công nghệ vi sinh, việc nuôi cấy vi sinh vật thu sinh khối để sản xuất các chế phẩm sinh học có giá trị được thực hiện trên môi trường nuôi cấy nào? Vì sao?
Phương pháp giải:
– Nuôi cấy không liên tục: trong môi trường nuôi cấy không liên tục – môi trường không được bổ sung chất dinh dưỡng mới và không được lấy đi các sản phẩm trao đổi chất, sự sinh trưởng của vi khuẩn bao gồm 4 pha cơ bản: pha tiềm phát, pha lũy thừa, pha cân bằng và pha suy vong.
– Nuôi cấy liên tục: trong môi trường nuôi cấy liên tục thường xuyên được bổ sung chất dinh dưỡng và loại bỏ các sản phẩm trao đổi chất.
Lời giải:
– Để thu được sinh khối để sản xuất các chế phẩm sinh học, người ta thường nuôi vi sinh vật trong môi trường nuôi cấy liên tục, do môi trường này luôn được bổ sung chất dinh dưỡng và loại bỏ chất thải, độc nên sinh khối vi sinh vật thu được nhiều, vi sinh vật không bị rơi vào pha suy vong nên hiệu quả cao trong sản xuất.
Giải Sinh học 10 trang 128 Kết nối tri thức
Câu hỏi 1 trang 128 Sinh học 10: Trình bày ảnh hưởng của các yếu tố bên ngoài đến sự sinh trưởng của vi sinh vật. Con người đã ứng dụng những hiểu biết này như thế nào trong lĩnh vực y tế và đời sống hàng ngày? Cho một vài ví dụ minh họa.
Phương pháp giải:
– Các yếu tố ảnh hưởng đến sự sinh trưởng của vi sinh vật:
+ Yếu tố vật lí: Nhiệt độ, độ ẩm, độ pH, ánh sáng, áp suất thẩm thấu.
+ Yếu tố hóa học: chất dinh dưỡng (protein, carbohydrat, lipid, ion khoáng,…); chất ức chế
Lời giải:
* Ảnh hưởng của các yếu tố bên ngoài đến sự sinh trưởng của vi sinh vật


* Con người đã ứng dụng các yếu tố ảnh hưởng đến VSV như:
– Con người dùng nhiệt độ cao để thanh trùng các chất lỏng, thực phẩm, dụng cụ,…nhiệt độ thấp để kìm hãm sinh trưởng của VSV.
– Điều chỉnh độ ẩm của lượng thực – thực phẩm, đồ dùng để bảo quản được lâu hơn bằng cách phơi khô, sấy khô.
– Dùng bức xạ điện từ để ức chế, tiêu diệt VSV.
…
Câu hỏi 2 trang 128 Sinh học 10: Nêu tác dụng của kháng sinh trong việc điều trị các bệnh do vi sinh vật gây ra. Thế nào là hiện tượng kháng kháng sinh, nêu nguyên nhân và tác hại của hiện tượng này.
Phương pháp giải:
– Trong quá trình sinh trưởng, VSV có thể tiết ra môi trường những chất có tác dụng ức chế sự phát triển hoặc tiêu diệt vi khuẩn, được gọi là chất kháng sinh. Ngày nay, kháng sinh không chỉ được chiết xuất từ các VSV mà còn được tổng hợp nhân tạo.
Lời giải:
– Tác dụng của kháng sinh trong việc điều trị các bệnh do vi sinh vật gây ra: Kháng sinh ức chế và tiêu diệt vi khuẩn theo nhiều cơ chế khác nhau như ức chế tổng hợp thành tế bào, protein hay nucleic acid,… của vi khuẩn. Dựa vào các đặc điểm này, con người đã phát triển và sử dụng rộng rãi các loại thuốc kháng sinh để điều trị các bệnh gây ra bởi vi khuẩn, giúp cứu sống nhiều người và thúc đẩy ngành chăn nuôi phát triển.
– Hiện tượng kháng kháng sinh: khả năng của các vi sinh vật như vi khuẩn, nấm hoặc ký sinh trùng sinh trưởng với sự hiển diện của một loại thuốc mà thông thường có thể giết chết hoặc hạn chế sự phát triển của chúng.
– Nguyên nhân của hiện tượng kháng kháng sinh:
+ Sử dụng thuốc kháng sinh không đúng theo chỉ định của bác sĩ, hoặc do bệnh nhân tự ý dùng thuốc.
+ Việc sử dụng rộng rãi kháng sinh trong chăn nuôi cũng làm tăng nguy cơ xuất hiện các loại VSV kháng thuốc, thậm chí đa kháng thuốc trên vật nuôi. Những VSV này có thể truyền sang người qua tiếp xúc, giết mổ và gene kháng kháng sinh có thể được truyền sang vi khuẩn gây bệnh ở người.
– Tác hại của hiện tượng kháng kháng sinh:
+ Không sử dụng được kháng sinh cũ đã từng có tác dụng cho chủng VSV.
+ Phải tăng liều kháng sinh
Câu hỏi 3 trang 128 Sinh học 10: Loét dạ dày từng được cho là do ăn nhiều thức ăn cay hoặc căng thẳng thần kinh, nay được biết là do vi khuẩn (Helicobacter pylori) gây ra. Với phát hiện này, việc điều trị loét dạ dày đã thay đổi như thế nào?
Phương pháp giải:
– Nhờ việc tìm ra nguồn gốc ây bệnh thực sự mà bác sĩ có thể đưa ra phác đồ và phương pháp điều trị bênh hợp lý.
Lời giải:
– Loét dạ dày từng được cho là do ăn nhiều thức ăn cay hoặc căng thẳng thần kinh, nên khi điều trị người ta tập trung điều trị trực tiếp các vết thương và điều trị tâm lý, dẫn đến việc điều trị không dứt khoát, bệnh nhân không chữa dứt khoát được bệnh.
– Nay được biết là do vi khuẩn (Helicobacter pylori) gây ra, bác sĩ sẽ tập chung điều trị kháng sinh, tiêu diệt triệt để nguồn gốc gây bênh.
Giải Sinh học 10 trang 129 Kết nối tri thức
Câu hỏi 1 trang 129 Sinh học 10: Vi sinh vật có những hình thức sinh sản nào? Nêu đặc điểm của mỗi hình thức đó và cho ví dụ.
Phương pháp giải:
Các vi sinh vật nhân sơ và vi sinh vật nhân thực đều có ba hình thức sinh sản chính là phân đôi, nảy chồi và hình thành bào tử.
Lời giải:
– Các vi sinh vật nhân sơ đều có ba hình thức sinh sản chính là phân đôi, nảy chồi và hình thành bào tử.

Câu hỏi 2 trang 129 Sinh học 10: Các hình thức sinh sản của vi sinh vật nhân sơ (vi khuẩn) có gì khác so với vi sinh vật nhân thực (vi nấm)?
Phương pháp giải:
– Các hình thức sinh sản ở vi sinh vật nhân sơ (vi khuẩn): chỉ sinh sản vô tính (phân đôi, hình thành bào tử, nảy chồi,..).
– Các hình thức sinh sản ở vi sinh vật nhân thực (vi nấm): sinh sản vô tính và hữu tính (tạo túi bào tử vô tính hoặc hữu tính), nảy chồi, tiếp hợp giao tử.
Lời giải:
Sự khác nhau giữa hình thức sinh sản của vi sinh vật nhân sơ (vi khuẩn) có gì khác so với vi sinh vật nhân thực (vi nấm) là:

Luyện tập và vận dụng (trang 130)
Giải Sinh học 10 trang 130 Kết nối tri thức
Câu 1 trang 130 Sinh học 10: Trong môi trường nuôi cấy không liên tục, số lượng tế bào vi khuẩn tăng nhanh nhất ở pha nào?
A. Pha lũy thừa B. Pha cân bằng
C. Pha suy vong D. Pha tiềm phát
Phương pháp giải:
– Vi khuẩn sinh trưởng trong môi trường nuôi cấy không liên tục theo 4 pha: pha tiềm phát, pha lũy thừa, pha cân bằng, pha suy vong.
– Đặc điểm sinh trưởng của vi khuẩn ở các pha
+ Pha tiềm phát: vi khuẩn thích nghi dần với môi trường, tổng hợp vật chất chuẩn bị cho sự phân chia.
+ Pha lũy thừa: VSV phân chia mạnh mẽ theo tiềm năng, số lượng tế bào tăng theo lũy thừa và đạt cực đại ở cuối pha.
+ Pha cân bằng: Tốc độ sinh trưởng và trao đổi chất của VSV giảm dần. Lượng tế bào sinh ra bằng lượng tế bào chết đi.
+ Pha suy vong: Số lượng tế bào ngày càng giảm dần do chất dinh dưỡng cạn kiệt, chất độc hại tích lũy ngày càng nhiều.
Lời giải:
– Đáp án: A
– Giải thích: Do trong môi trường nuôi cấy không liên tục, tại pha lũy thừa VSV phân chia mạnh mẽ theo tiềm năng, số lượng tế bào tăng theo lũy thừa và đạt cực đại ở cuối pha.
Câu 2 trang 130 Sinh học 10: Hãy giải thích vì sao người ta có thể điều khiển nhiệt độ, độ ẩm, độ pH, áp suất thẩm thấu để bảo quản thực phẩm.
Phương pháp giải:
– Thực phẩm bị hư hỏng nguyên nhân là do hoạt động của các VSV có trong môi trường xung quanh.
– VSV chịu ảnh hưởng của các yếu tố: nhiệt độ, độ ẩm, độ pH, áp suất thẩm thấu,…
Lời giải:
– Nguyên nhân gây hư hỏng thực phẩm là do sự phân giải của VSV. Vì vậy, dựa vào các yếu tố ảnh hưởng (nhiệt độ, độ ẩm, độ pH, áp suất thẩm thấu,…) đến hoạt động của VSV mà người ta có thể điều chỉnh tăng giảm các yếu tố này nhằm tiêu diệt hoặc ức chế sự sinh trưởng của VSV giúp bảo quản được thực phẩm lâu hơn.
Câu 3 trang 130 Sinh học 10: Vi sinh vật và hoạt động phân giải chất hữu cơ của chúng là nguyên nhân chủ yếu gây hỏng thực phẩm. Dựa vào những kiến thức đã học, em hãy đề xuất một số phương pháp bảo quản thực phẩm.
Phương pháp giải:
– Thực phẩm bị hư hỏng nguyên nhân là do hoạt động của các VSV có trong môi trường xung quanh.
– VSV chịu ảnh hưởng của các yếu tố: nhiệt độ, độ ẩm, độ pH, áp suất thẩm thấu,…
Lời giải:
Đề xuất một số phương pháp bảo quản thực phẩm:
– Bảo quản thức ăn ở nhiệt độ thấp (tủ lạnh).
– Bảo quản bằng thay đổi áp suất thẩm thấu (làm siro bằng hoa quả ngâm đường).
– Bảo quản bằng thay đổi độ pH (muối chua),..
Câu 4 trang 130 Sinh học 10: Hãy giải thích vì sao các bệnh do vi sinh vật gây ra (bệnh tả, nấm,…) dễ xuất hiện và phát triển thành dịch ở những vùng nhiệt đới hơn so với vùng ôn đới. Vì sao thực phẩm và đồ dùng ở vùng nhiệt đới rất nhanh bị hỏng nếu không được bảo quản đúng cách?
Lời giải:
* Các bệnh do vi sinh vật gây ra (bệnh tả, nấm,…) dễ xuất hiện và phát triển thành dịch ở những vùng nhiệt đới hơn so với vùng ôn đới vì đặc điểm khí hậu ở hai vùng có sự khác biệt:
+ Vùng nhiệt đới thường khí hậu nóng và mưa nhiều quanh năm.
Câu 5 trang 130 Sinh học 10: Bạn A bị cảm lạnh, đau họng, ho, sổ mũi, nhức đầu. Để đỡ mất thời gian đi khám, bạn đã ra hiệu thuốc mua kháng sinh về nhà tự điều trị. Theo em, việc làm của bạn là nên hay không lên? Vì sao?
Phương pháp giải:
– Tác dụng của kháng sinh trong việc điều trị các bệnh do vi sinh vật gây ra: Kháng sinh ức chế và tiêu diệt vi khuẩn theo nhiều cơ chế khác nhau như ức chế tổng hợp thành tế bào, protein hay nucleic acid,… của vi khuẩn. Dựa vào các đặc điểm này, con người đã phát triển và sử dụng rộng rãi các loại thuốc kháng sinh để điều trị các bệnh gây ra bởi vi khuẩn, giúp cứu sống nhiều người và thúc đẩy ngành chăn nuôi phát triển.
– Hiện tượng kháng kháng sinh: khả năng của các vi sinh vật như vi khuẩn, nấm hoặc ký sinh trùng sinh trưởng với sự hiển diện của một loại thuốc mà thông thường có thể giết chết hoặc hạn chế sự phát triển của chúng.
– Tác hại của hiện tượng kháng kháng sinh:
+ Không sử dụng được kháng sinh cũ đã từng có tác dụng cho chủng VSV.
+ Phải tăng liều kháng sinh
Lời giải:
– Theo em bạn không nên mua kháng sinh về nhà tự điều trị. Vì khi bạn tự mua thuốc về điều trị, bạn không thể nắm rõ được liều lượng thuốc phù hợp với bản thân, có thể dẫ đến hiện tượng nhờn thuốc.
– Tác dụng của kháng sinh trong việc điều trị các bệnh do vi sinh vật gây ra: Kháng sinh ức chế và tiêu diệt vi khuẩn theo nhiều cơ chế khác nhau như ức chế tổng hợp thành tế bào, protein hay nucleic acid,… của vi khuẩn. Dựa vào các đặc điểm này, con người đã phát triển và sử dụng rộng rãi các loại thuốc kháng sinh để điều trị các bệnh gây ra bởi vi khuẩn, giúp cứu sống nhiều người và thúc đẩy ngành chăn nuôi phát triển.
– Hiện tượng kháng kháng sinh: khả năng của các vi sinh vật như vi khuẩn, nấm hoặc ký sinh trùng sinh trưởng với sự hiển diện của một loại thuốc mà thông thường có thể giết chết hoặc hạn chế sự phát triển của chúng.
– Nguyên nhân của hiện tượng kháng kháng sinh:
+ Sử dụng thuốc kháng sinh không đúng theo chỉ định của bác sĩ, hoặc do bệnh nhân tự ý dùng thuốc.
+ Việc sử dụng rộng rãi kháng sinh trong chăn nuôi cũng làm tăng nguy cơ xuất hiện các loại VSV kháng thuốc, thậm chí đa kháng thuốc trên vật nuôi. Những VSV này có thể truyền sang người qua tiếp xúc, giết mổ và gene kháng kháng sinh có thể được truyền sang vi khuẩn gây bệnh ở người.
– Tác hại của hiện tượng kháng kháng sinh:
+ Không sử dụng được kháng sinh cũ đã từng có tác dụng cho chủng VSV.
+ Phải tăng liều kháng sinh
Lý thuyết Sinh học 10 Bài 21: Trao đổi chất, sinh trưởng và sinh sản ở vi sinh vật
I. Quá trình tổng hợp và phân giải các chất ở vi sinh vật
1. Quá trình tổng hợp:
Sinh tổng hợp (đồng hóa) là quá trình tế bào sử dụng năng lượng để liên kết các phân tử đơn giản thành các phân tử hữu cơ phức tạp cần thiết.
a) Tổng hợp carbohydrate:
Vi sinh vật tổng hợp glucose theo 2 cách:
Quang hợp ở vi khuẩn lam, tảo là con đường phổ biến và quan trọng nhất.
Quang khử ở vi khuẩn màu lục, màu tía
Hóa tổng hợp ở vi khuẩn sắt, vi khuẩn nitrate

Glucose làm nguyên liệu xây dựng tế bào và dự trữ năng lượng, Chitin cấu tạo nấm, peptidoglycan tạo thành vi khuẩn và cellulose cấu tạo thành tảo lục.

b) Tổng hợp protein:
Phần lớn vi sinh vật có khả năng tổng hợp được toàn bộ 20 loại amino acid, trong khi còn người không làm được.
Một số vi sinh vật (vi khuẩn lam, Rhizobium) có thể chuyển hóa N2 của khí quyển thành ammonia (NH3) cung cấp nitrogen cho cả hệ sinh thái.

c) Tổng hợp lipid:
Ở vi sinh vật, lipid được tổng hợp từ các acid béo và glycerol. Lipid là thành phần chính của màng tế bào và màng ngoài của vi khuẩn Gram âm.
d) Tổng hợp nucleic acid:
Nucleotide được tổng hợp từ 1 gốc đường 5 cacbon + amino acid + phosphoric acid. Tất cả các phản ứng đều sử dụng ATP.

2. Phân giải các chất:
Các vi sinh vật dị dưỡng phân giải các hợp chất hữu cơ do vi sinh vật khác cung cấp để lấy làm nguyên liệu cho hoạt động sống của chúng.

II. Sinh trưởng của quần thể vi khuẩn
Sinh trưởng của quần thể sinh vật là sự tăng lên về mặt số lượng tế bào trong quần thể.
Thời gian thế hệ (g) là thời gian tính từ khi tế bào sinh ra đến khi tế bào đó phân chia, thời gian thế hệ của một quần thể là hằng số.
Mỗi loài có một thời gian thế hệ khác nhau.
Ví dụ: Thời gian thế hệ của E.coli là g = 20 phút, còn ở vi khuẩn lao g = 12 giờ.

Ở điều kiện lí tưởng, sau n lần phân chia từ No tế bào ban đầu, trong thời gian t, số tế bào tạo thành Nt là:

1. Nuôi cấy không liên tục:
Môi trường nuôi cấy không liên tục là môi trường không được bổ sung chất dinh dưỡng mới và không được lấy đi các chất thải từ quá trình trao đổi chất. Sinh trưởng của vi khuẩn chia thành 4 pha:

2. Nuôi cấy liên tục:
Môi trường nuôi cấy liên tục là môi trường thường xuyên được bổ sung chất dinh dưỡng và loại bỏ các sản phẩm trao đổi chất. Vi khuẩn nuôi để sản xuất sinh khối (enzyme, vitamin …).
III. Các yếu tố ảnh hưởng đến sinh trưởng của quần thể vi sinh vật:
Trong tự nhiên, có nhiều yếu tố ảnh hưởng đến tốc độ sinh trưởng của quần thể sinh vật.
1. Các yếu tố vật lí:

2. Các yếu tố hóa học
a) Chất dinh dưỡng:
Vi sinh vật chỉ có thể tồn tại trong môi trường có chất dinh dưỡng (protein, carbohydrate …) và các nhân tố sinh trưởng (amino acid, vitamin hoặc nguyên tố vi lượng).
Vi sinh vật không tự tổng hợp được các nhân tố sinh trưởng gọi là vi sinh vật khuyết dưỡng, loài có thể tự tổng hợp được gọi là vi sinh vật nguyên dưỡng.

b) Chất ức chế:
Một số chất hóa học ức chế sự sinh trưởng của vi sinh vật là:

3. Kháng sinh, ý nghĩa của kháng sinh và tác hại của việc lạm dụng kháng sinh:
Vi sinh vật trong quá trình sinh trưởng có thể tiết ra môi trường chất ức chế phát triển hoặc tiêu diệt vi khuẩn khác, gọi là chất kháng sinh.
Dựa vào đặc điểm này, con người đã phát triển và sử dụng rộng rãi các loại thuốc kháng sinh điều trị bệnh gây ra bởi vi khuẩn.
Lạm dụng thuốc kháng sinh không theo chỉ dẫn của bác sĩ gây hiện tượng kháng thuốc.
Lạm dụng thuốc kháng sinh trong chăn nuôi cũng tăng nguy cơ xuất hiện vi khuẩn kháng thuốc.
IV. Hình thức sinh sản ở vi sinh vật
Vi sinh vật có 3 hình thức sinh sản chính: phân đôi, hình thành bào tử và nảy chồi.
1. Phân đôi:
Là hình thức sinh sản phổ biến nhất, tế bào mẹ phân chia thành 2 tế bào con giống nhau. Có 2 hình thức phân đôi: vô tính (vi khuẩn nhân sơ) và hữu tính (trùng giày).

2. Sinh sản bằng bào tử:
Nấm và vi khuẩn sinh sản bằng bào tử dạng vô tính hoặc hữu tính. Có nhiều loại bào tử: ngoại bào tử chỉ có màng mỏng giúp sinh sản, nội bào tử có lớp vỏ dày chứa calcium dipicolinate giúp vi khuẩn tiềm sinh ở điều kiện bất lợi.

3. Nảy chồi:
Là phương thức sinh sản vô tính đặc trưng của số ít vi khuẩn quang dưỡng (vi khuẩn tía, nấm men …). Một cá thể con sẽ dần hình thành ở một phần cơ thể mẹ, sau khi trưởng thành sẽ tách ra và sống độc lập.

Sơ đồ tư duy trao đổi chất, sinh trưởng và sinh sản ở vi sinh vật:

Xem thêm các bài giải SGK Sinh học lớp 10 Kết nối tri thức hay, chi tiết khác:
Bài 20: Sự đa dạng và phương pháp nghiên cứu vi sinh vật
Bài 22: Vai trò và ứng dụng của vi sinh vật
Bài 23: Thực hành: Một số phương pháp nghiên cứu vi sinh vật thông dụng, tìm hiểu về các sản phẩm công nghệ vi sinh vật và làm một số sản phẩm lên men từ vi sinh vật
Bài 24: Khái quát về virus